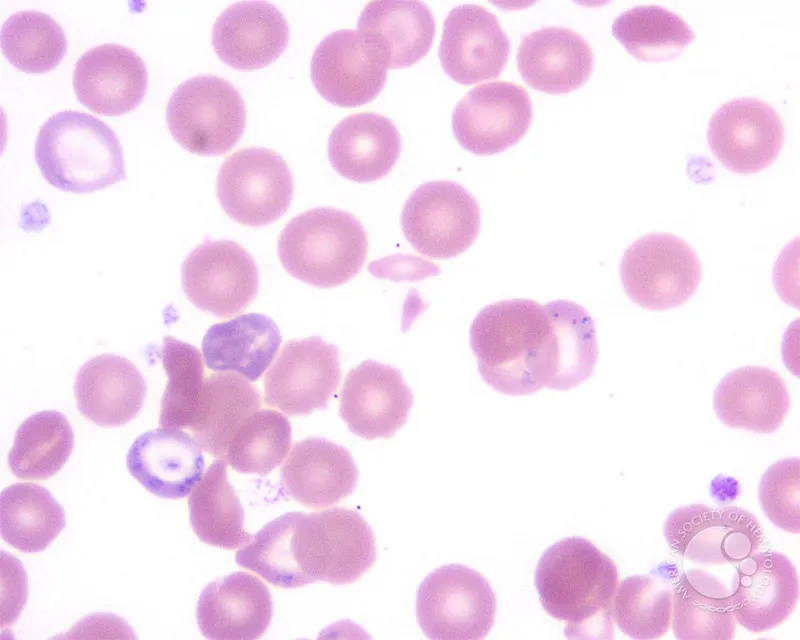
Basophilic stippling in lead poisoning peripheral smear

General Approach - Poisoning Protocol Playbook
- Decontamination
- Gastric Lavage: <1 hr post-ingestion, life-threatening. Contra: caustics, hydrocarbons.
- Activated Charcoal (AC): <1 hr, 1 g/kg.
⭐ AC ineffective for: Pesticides/Potassium, Hydrocarbons, Alcohols/Acids/Alkalis, Heavy Metals, Iron, Lithium, Solvents (PHAILS).
- Whole Bowel Irrigation (WBI): Sustained-release, body packers, Fe, Li.
- Enhanced Elimination
- MDAC (Multiple Dose AC): Theophylline, Phenobarbital, Carbamazepine, Dapsone, Quinine.
- Alkaline Diuresis: Salicylates, Phenobarbital. Target urine pH 7.5-8.5.
- Hemodialysis: 📌 I STUMBLE (Isopropanol, Salicylates, Theophylline, Uremia, Methanol, Barbiturates (long), Lithium, Ethylene glycol).
- Antidotes: Specific agents to counteract poison effects. Principles: competitive antagonism, chelation.

Toxidrome Detective - Syndrome Sleuthing
Recognize patterns! Key features differentiate common toxidromes:
| Toxidrome | HR | BP | Pupils | Skin | Bowel | MS | Key Features / Mnemonics |
|---|---|---|---|---|---|---|---|
| Sympathomimetic | ↑ | ↑ | Mydriasis | Sweaty, Warm | ↑ | Agitated | Seizures, Tremors |
| Anticholinergic | ↑ | N/↑ | Mydriasis | Dry, Hot, Red | ↓ | Delirious | 📌 Mad as a hatter... Urinary retention |
| Cholinergic (M) | ↓ | N/↓ | Miosis | Sweaty, Salivation | ↑ | Confused | 📌 SLUDGE-BAM |
| Cholinergic (N) | ↑ | ↑ | Mydriasis (var) | Sweaty | N/↑ | Weak/Paralysis | Fasciculations, Muscle weakness |
| Opioid | ↓ | ↓ | Miosis (Pinpoint) | Cool, Clammy | ↓ | Depressed | ↓Resp Rate, Coma |
| Sedative-Hypnotic | ↓ | ↓ | Variable | Cool, Dry | ↓ | Depressed | ↓Resp Rate, Slurred speech, Ataxia |
| Serotonin Synd. | ↑ | N/↑ | Mydriasis | Sweaty, Hot | ↑ | Agitated | Clonus, Hyperreflexia, Hyperthermia |
⭐ Mydriasis: Sympathomimetic (sweaty skin) vs. Anticholinergic (dry skin). Miosis: Opioids, Organophosphates (cholinergic).
Key Culprits & Cures 1 - Paracetamol & Pals
- Paracetamol (Acetaminophen)
- Toxic dose: >150 mg/kg or >10-12g. Mechanism: NAPQI (toxic metabolite) depletes glutathione.
- Stages: I (N/V, malaise) → II (RUQ pain, ↑LFTs) → III (hepatic failure, encephalopathy, coagulopathy, acidosis) → IV (recovery).
- Rumack-Matthew nomogram guides N-acetylcysteine (NAC) use. IV NAC: 150 mg/kg loading dose, then maintenance.

- Salicylates (Aspirin)
- Mechanism: Uncouples oxidative phosphorylation; stimulates respiratory center.
- Clinical Features: Tinnitus, vertigo, N/V, hyperventilation (respiratory alkalosis) → metabolic acidosis (↑anion gap), fever, altered mental status.
- Treatment: Supportive (ABCs), activated charcoal (if <1-2h), IV fluids, $NaHCO_3$ for alkaline diuresis (urine pH 7.5-8.5), glucose, K+ replacement, hemodialysis for severe cases.
- Organophosphates (OP) & Carbamates
- Mechanism: Acetylcholinesterase (AChE) inhibition → cholinergic crisis (excess acetylcholine).
- Clinical Features: 📌 DUMBELS (Diarrhea, Urination, Miosis, Bronchospasm/Bradycardia, Emesis, Lacrimation, Salivation) or SLUDGE + Killer Bs (Bradycardia, Bronchorrhea, Bronchospasm). Muscle fasciculations, weakness, paralysis.
- Treatment: Decontamination, Atropine (muscarinic antagonist, titrate to effect e.g. drying secretions), Pralidoxime (PAM) for OP poisoning (reactivates AChE, especially for nicotinic effects like muscle weakness; give early <24-48h).
⭐ Pralidoxime (PAM) is effective for nicotinic effects of organophosphate poisoning and should be given early. It is generally not recommended for carbamate poisoning as carbamates spontaneously detach from AChE, and PAM may even be harmful in some carbamate (e.g., Sevin) poisonings.
Key Culprits & Cures 2 - Alcohols & Heavy Hitters
- Toxic Alcohols (Methanol, Ethylene Glycol)
- Sources: Methanol (solvents), EG (antifreeze).
- Toxic metabolites: Formic acid (M), Glycolic/Oxalic (EG).
- Features: HAGMA (📌 MUDPILES), ↑ Osmolar gap.
- Osmolar Gap = Measured Osmolality - $(2 \times Na + Glucose/18 + BUN/2.8)$
- Rx: Fomepizole/Ethanol (target 100-150 mg/dL), HD.
> ⭐ Fomepizole preferred over ethanol (easier dosing, fewer side effects), but costly.
-
Opioids
- Triad: CNS/resp depression, miosis.
- Rx: Naloxone (0.4-2 mg IV/IM/SC).
-
Benzodiazepines
- Rx: Flumazenil (0.2 mg IV). ⚠️ Seizure risk.
-
Heavy Metals
- Lead: Basophilic stippling, Burton's line. Rx: EDTA, DMSA, BAL.
- Arsenic: Mees' lines, garlic breath. Rx: BAL, DMSA.

- Mercury: Minamata. Rx: BAL, DMSA, Penicillamine.
- Lead: Basophilic stippling, Burton's line. Rx: EDTA, DMSA, BAL.
High‑Yield Points - ⚡ Biggest Takeaways
- Know key antidotes: N-acetylcysteine (paracetamol), naloxone (opioids), flumazenil (benzos), atropine/pralidoxime (OP poisoning).
- Identify toxidromes: opioid (miosis, ↓RR), cholinergic (DUMBELS), anticholinergic (mad, blind, dry), sympathomimetic (agitated, ↑HR).
- ↑Anion gap (AGMA) common: MUDPILES (methanol, salicylates, ethylene glycol). Fomepizole for toxic alcohols.
- Organophosphate poisoning: aggressive atropinization and pralidoxime.
- Activated charcoal ineffective for metals, alcohols, corrosives, lithium.
- Salicylate toxicity: manage with urine alkalinization and hemodialysis if severe.
Unlock the full lesson and continue reading
Signup to continue reading this lesson and unlimited access questions, flashcards, AI notes, and more